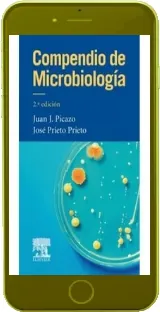
Descarga Compendio de Microbiologia de Picazo de la Garza en español completo eBook

«Compendio de Microbiologia» | Picazo de la Garza - Descargar PDF o ePub 2022
- Nombre del libro: Compendio de Microbiologia
- Autor: Picazo de la Garza
- Día de publicación libro: 2022-01-10
- Editorial: Elsevier
- Idioma: Español
- Género o Colección: Biología
- ISBN: 9788490229217
- Número de páginas: 736 (368 MB)
- Incluye un resumen de 37 páginas
- Descripción o resumen del libro: Nueva edición que continua con la misma filosofía, se trata de un compendio en un formato de bolsillo, muy manejable y asequible y que presenta los conceptos fundamentales y esenciales que el alumno debe saber. Se han revisado y actualizado todos los contenidos para ofrecer un enfoque más práctico que facilite la contextualización de kis concpetos teóricos. Se estructura en dos grandes apartados, microbiología general, donde encontrarán una detallada descripción de los principales microorganismos causantes de patología humana y microbiología clínica, donde se describen los grandes síndromes clínicos infecciosos. Se dirige especialmente al estudiante de medicina, pero también será de utlidad para especialistas en formación y para estudiantes de otros grados de ciencias de la salud.
- Tiempo estimado de lectura: 10H33M04S
- Otras categorías, géneros o colecciones: Microbiología
- Formatos de lectura disponibles: PDF, WORD, EPUB, TXT, PNG, DOC, DOCX, CBR, KFX. Comprimidos en ZIP, DjVu, RAR
- Servidores de descarga: Google Drive, Dropbox, Amazon Drive, Racaty, ZippyShare, MediaFire, DepositFiles, Microsoft OneDrive
- Encuadernación: Tapa Blanda
- Precio aproximado: 8,18 USD (dólares americanos)
- Dimensiones: 174,69x154,48x22,04mm
- Peso: 237,23g
- Impreso por: BG
- Publicado en: Santiago de Cuba
- Valoración del libro: 7,72 de 10
- Votos: 306
- Reseñado por: Keilee Octavia Gremer Siraj
- Valoración a la reseña: 9,79 de 10
- Fecha de la reseña: 2022-01-21
- Fecha publicación de este artículo: 2022-01-27
- Última actualización: 2022-02-12
Votar:







